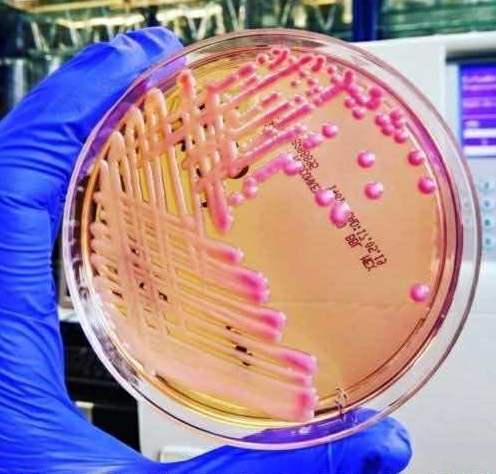

Само в Lupa.bg: Разследват смъртта на двама в столична болница заради бактерия
Вълна от разкази за заболели с потенциално опасната Клебсиела заля мрежата след разкритието за епидемията
Близките на двама пациенти, заразени с вътреболнична бактериална инфекция и впоследствие починали, са завели дела срещу столична болница, научи Lupa.bg. Новината идва на фона на крайно обезпокоителната информация от началото на седмицата, че всъщност в страната върлува епидемия от бактерията Клебсиела пневмония.
Патогенът е обхванал огромна част от лечебните заведения в страната и е изключително резистентен на антибиотично лечение, като антибиограмите на голяма част от пациентите с вече установената инфекция след болничния им престой съдържат едва по един потенциално ефикасен препарат за лечение.
Алармата пръв би доц. Иван Иванов, завеждащ Националната референтна лаборатория "Контрол и мониториране не антибиотичната резистентност" в НЦЗПБ. За вътреболничните инфекции у нас се говори от години, като има и специална наредба за спазването и упражняването на контрола върху тях при определни условия на работа на медиците и немедицинския персонал, а от друга страна, за редовно пробовземане и микробиология.
Оказва се обаче, че пробойните са много и страната е изправена пред колапс. Десетки пациенти ежедневно се изписвали от лечебните заведения с мултирезистентната бактерия, без изобщо да знаят за нея.
Ето я гадината, развила се в лабораторни условия
Клебсиела е патоген, който при здрав човек обичайно обитава чревната флора, но може да се превърне в животозастрашаващ и да стане опортюнистична инфекция при пациенти с отслабен имунитет, изискващи определена терапия и предимно при възрастни, деца и озовали се в интензивните отделения.
По информация на медията точно такъв е случаят на двамата починали в рамките на годината - близките им съдят конкретната лечебница заради липсата на превенция за развитието на вътреболничната инфекция с клебсиела. Става въпрос за едно и също отделение, в един и същи период. Документацията по двата казуса вече е в ръцете на Изпълнителната агенция за медицински надзор. Междувременно обаче новината от доц. Иванов за масовото разпространение на клебсиелата доведе до надигането на огромна вълна от разкази в мрежата на пациенти, сдобили се с нея - при хирургични интервенции, катетеризации и раждания.
По наредбата за утвърждаването на медицинския стандарт по превенция и контрол на вътреболничните инфекции, болниците се делят на три груби според специфичния риск за това и изискват съответен брой специалисти, които да се борят с опасните агенти. Във високорисковата групи попадат клиниките по анестезиология и интензивно лечение, по хирургия, по неврохирургия, по урология, по акушерство и гинекология, по неонатология, по детски болести, по ортопедия и травматология, по инфекциозни болести, по онкология, за хемодиализа, за лечение на хронични заболявания.
При тях не само пробовземането от повърхности, инструменти и медицински персонал трябва да се прави редовно и по всички правила на наредбата, но и микробиологичният анализ е със завишена честота. Публична тайна обаче е, че на много места в страната именно с цел да не се стигне до нарушаване на правилата, разпоредени от нормативната уредба за дейността на болниците и съответно налагането на глоби или дори сваляне на нивото на компетентност, въпросните натривки се правят след... щателна дезинфекция.
Това означава, че специалистите, заети с дейността в съответното отделение или клиника, взимат пробите след като повърхностите, ръкавиците или скалпелите и другите медицински изделия, са били подложени на химическа обработка и де факто резултатът от микробиологичния анализ за наличието на бактерии е компрометиран. Това силно затруднява и борбата с въпросните патогени (не само клебсиела пневмония - б.р.).
От друга страна, не навсякъде се въвежда стриктен контрол и санитарен кордон за лечението и съответно изолирането на пациенти с вече установената инфекция.
Редакцията на Lupa.bg ще държи своите читатели в течение за съдебните казуси около двамата покойници и предприетите действия от здравното ведомство за ограничаване на вътреболничните инфекции в родните лечебни заведения.